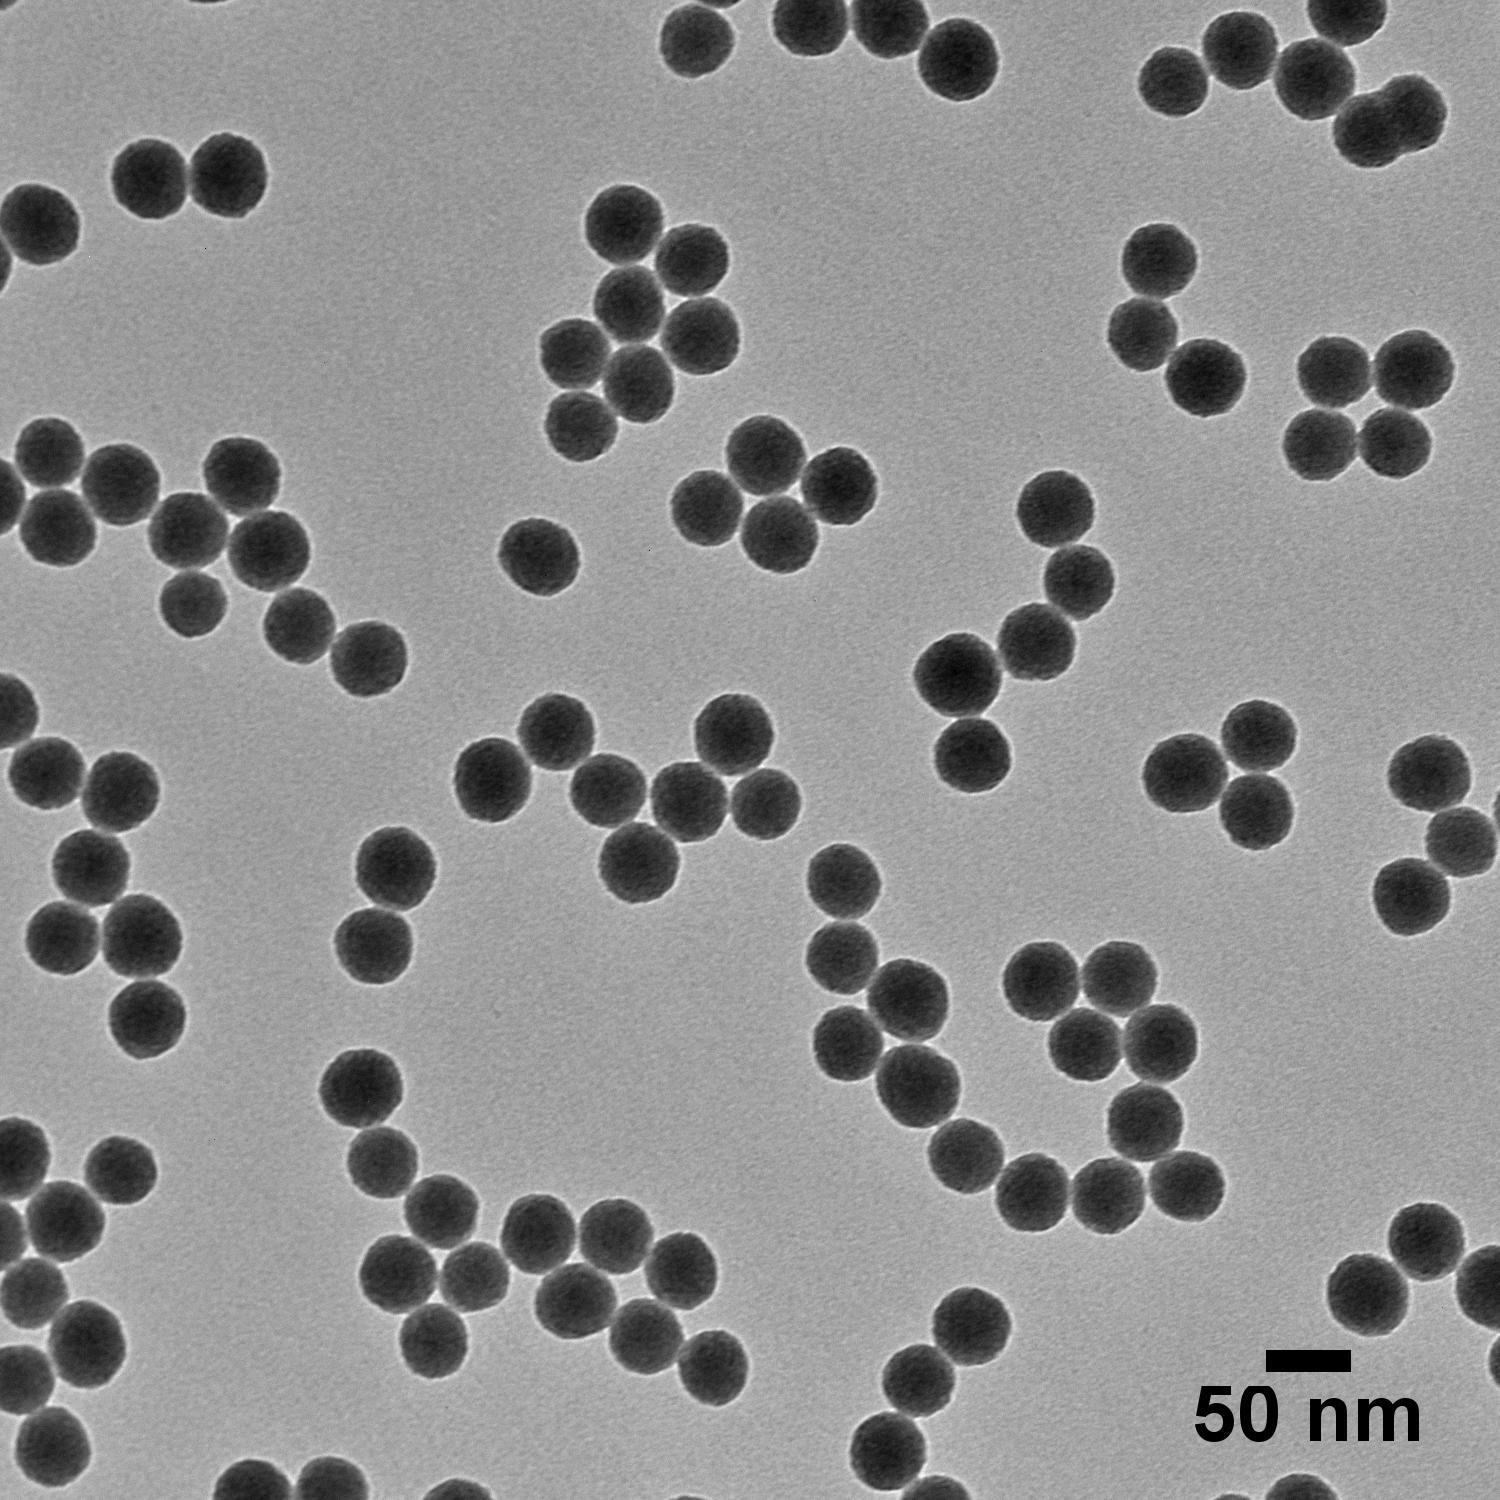

Reference materials are critical for maintaining the framework of scientific measurement. They play a vital role in ensuring the quality and metrological traceability of products, facilitating reliable comparisons across laboratories and industries, and validating analytical methods to guarantee accurate and precise characterization of materials. Nanomaterials offer several advantages over traditional materials in this arena. They may offer enhanced stability – gold nanoparticles are inert to environmental factors and are highly resistant to degradation over time. This translates to a longer shelf life and more consistent performance over time compared to some traditional standards. Nanoscale standards can also offer more precise properties to allow for highly specific and sensitive measurements, which is not always achievable with bulk materials.

However, developing robust reference standards presents a unique challenge in nanotechnology. Due to the inherent properties of nanoparticles, such as their small size and high surface area, achieving the shape purity, size homogeneity, and chemical stability necessary for a reference material can be particularly demanding. Some of the key things to consider when using nanoparticles as reference standards include:
Composition, Size, Shape, Surface chemistry and Charge
These critical properties need to be tightly controlled and measured during fabrication and throughout the lifetime of any nanoparticle reference material.
Colloidal Stability
The degree of particle aggregation and corresponding hydrodynamic size needs to be known and tracked with time.
Element Concentration
All elements including the constituent materials of the nanoparticle and any residual chemicals in solution must be quantified.
Optical Properties, Surface Area, Solution pH, and Endotoxin Levels
Thorough characterization and monitoring of parameters are also important for many reference materials.
These requirements highlight the need for advanced techniques to ensure the reliability and accuracy of nanomaterial-based reference standards to facilitate wider use in scientific measurement.
nanoComposix specializes in precisely engineered, highly characterized nanoparticles, and offers a variety of off-the-shelf products suitable for use as nanoscale reference materials. Specific examples are included below.
Nanoparticle Reference Material Application Highlights
Conventional methods for determining pore size limitations in ultrafiltration membranes fall short at the nanoscale. nanoComposix provided its most monodisperse gold nanoparticles for use as a reference standard in determining the functional pore size of ultrafiltration systems. Ultra Uniform gold particles have an exceptionally narrow size distribution, with a coefficient of variation below 5%, making them ideal size standards. By passing a mixture of these gold nanoparticles through the membrane and employing single particle detection techniques, researchers can gain valuable insights into the membrane's functionality. The specific size of nanoparticles that pass through the membrane provides a direct measure of its effective pore size, offering a fast and sensitive method for evaluating ultrafiltration membranes at the nanoscale.
Read more about nanoComposix Ultra Uniform gold nanoparticles


In collaboration with NIST scientists, nanoComposix developed a dried silver nanoparticle formulation that can be re-dispersed without any aggregation (RM 8017). Shelf life stability tests determined that these silver nanoparticles have an extended, multi-year shelf life. nanoComposix fabricated and delivered material for over 1000 reference material samples.


Next-generation photometry instruments require ever-increasing accuracy and sensitivity for light measurement. nanoComposix has provided custom formulations of silica nanomaterials for use as reference standards for the calibration of such instruments. Silica nanoparticles are a promising reference material for calibrating these instruments, as their near-perfect spherical shape and well-defined size distribution minimize light scattering variations, ensuring consistent light interaction. Additionally, silica's inherent high purity and well-understood optical properties make its response to light predictable and reliable. By using these nanoparticles as a standard, photometry instruments can be precisely calibrated, leading to more accurate and dependable light measurements.

Single particle inductively coupled plasma mass spectrometry (sp-ICP-MS) demands highly precise reference materials for accurate analysis. nanoComposix provides bimetallic core-shell nanoparticles with tunable core diameter and shell thickness, providing a reference material with a well-defined atomic ratio for scientists to determine particle size and concentration in their samples with exceptional accuracy.


In addition to sp-ICP-MS, other applications such as Nano Tracking Analysis (NTA) and Tunable Resistive Pulse Sensing (TRPS) require precise nanoparticle formulations with a known particle number concentration. nanoComposix provides Ultra Uniform Particle Number Standards based on the highly monodisperse Ultra Uniform gold nanoparticle line in 30 nm, 50 nm, and 100 nm particle sizes. Ultra Uniform products are verified by sp-ICP-MS calibrated using the colloidal gold standard from the National Measurement Laboratory at LGC. nanoComposix number standards are provided at 108 particles/mL and provide the thorough characterization and careful formulation required for highly sensitive measurements.
For sensitive NTA measurements of even the smallest nanoComposix number standard, consider the ViewSizer 3000 from Horiba Scientific.



nanoComposix Nanoparticles as Standards in Literature
The selected articles below highlight the use of nanoparticles made by nanoComposix used as standard reference materials in applications such as single particle ICP-MS and nanotoxicology investigations.
- Aramendía, Maite, et al. “A novel approach for adapting the standard addition method to single particle-ICP-MS for the accurate determination of NP size and number concentration in complex matrices.” Analytica Chimica Acta, vol. 1205, 2022. doi.org/10.1016/j.aca.2022.339738
- Azimzada, Agil, et al. “Quantification and characterization of Ti-, Ce-, and Ag-nanoparticles in global surface waters and precipitation.” Environmental Science & Technology, vol. 55, no. 14, 2021. doi.org/10.1021/acs.est.1c00488
- Calderón-Jiménez, Bryan, et al. “Silver nanoparticles: Technological Advances, societal impacts, and Metrological challenges.” Frontiers in Chemistry, vol. 5, 2017. doi.org/10.3389/fchem.2017.00006
- Djorović, Aleksa, et al. “Extinction-to-absorption ratio for sensitive determination of the size and dielectric function of gold nanoparticles.” ACS Nano, vol. 14, no. 12, 2020. doi.org/10.1021/acsnano.0c08431
- Geiss, Otmar, et al. “Determination of the transport efficiency in SPICP-MS analysis using conventional sample introduction systems: An interlaboratory comparison study.” Nanomaterials, vol. 12, no. 4, 2022, p. 725. doi.org/10.3390/nano12040725
- Merrifield, Ruth C., et al. “Single-particle inductively coupled plasma mass spectroscopy analysis of size and number concentration in mixtures of monometallic and bimetallic (core-shell) nanoparticles.” Talanta, vol. 162, 2017. doi.org/10.1016/j.talanta.2016.09.070
- Pace, Heather E., et al. “Determining transport efficiency for the purpose of counting and sizing nanoparticles via single particle inductively coupled plasma mass spectrometry.” Analytical Chemistry, vol. 83, no. 24, 2011. doi.org/10.1021/ac201952t
